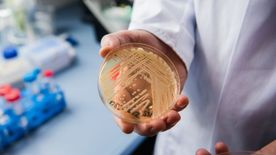

A 16. században tényleg halálra táncolták magukat az emberek – A nagy táncjárvány története


Az 1518-as év emlékezetes volt a strasbourgiak számára, ugyanis egy megmagyarázhatatlan táncjárvány vette kezdetét a nyár közepén.

A mai Franciaországhoz tartozó elzászi város a 16. században még a Német-római Birodalomhoz tartozott. Itt élt egy Frau Troffea nevű hölgy, aki egy júliusi napon se szó, se beszéd, egyszer csak megállás nélküli táncba kezdett a város utcáin. A többi lakos egy ideig csupán csodálkozva bámulta a hölgy rángó mozdulatait, ám Frau Troffea tánca csak nem akart szűnni. Persze vannak feljegyzések, melyek szerint az asszony néha elájult a kimerültségtől, de aztán felkelt, és újra ropni kezdte az akkor igencsak modern stílusúnak számító koreográfiáját.
Éppúgy, ahogy ma is kopírozzuk az előttünk ásítozót vagy hahotázót, a német bámészkodók is elkezdték utánozni Frau Troffea tánclejtését. Egyre többen csatlakoztak be, míg végül több százan rángatóztak együtt bármiféle zenei kíséret nélkül.
Ekkor már a középkori orvosok is beleavatkoztak a történésekbe. Csakhogy először elég érdekes ötlettel rukkoltak elő gyógyírként, mondván, hogy ha már mindenki táncba kezdett, akkor miért is ne lehetne ezt a napokon és éjeken át tartó „mulatságot” végigülni? Vagyis erre a különös betegségre a „táncold ki magad” receptet írták fel az akkori gyógyászok.
Táncparkettet húztak fel, valamint zenészeket és erős legényeket béreltek fel, akik segítették a táncoslábúakat, hogy azok talpon maradva rophassák. Mindezt abban a hiszemben tették, hogy az őrjöngő táncosok majd úgyis kifáradnak, és akkor végre az egész hűhó véget ér.
Ennek a következménye viszont sokkal tragikusabb volt, mint azt hitték volna. Ekkor már vagy négyszázan táncoltak, ám az orvosok által előrít kitáncoltatásnak nem gyógyulás, hanem sok esetben halál lett a vége.
Középkori feljegyzések szerint a strasbourgi táncmániában többen is odavesztek kimerültség, kiszáradás, szívroham vagy agyvérzés miatt. A „betegek” továbbá annyira megerőltették testüket a halálos táncban, hogy a felduzzadt lábukba tóduló vér miatt többen vérrel áztatott cipőkben táncoltak.
Mivel az első megoldás kevésbé volt sikeres, így az új gyógyírt inkább vallási szempontból közelítették meg.

Az orvosok szerint a bűnös táncolókat maga Szent Vitus büntette meg, a mulatozóknak tehát bűnbánatot kellett mutatniuk ennek a szentnek. A nyilvános táncot (sőt a zenét is) betiltották, az erkölcstelennek és bűnösnek titulált táncosokat pedig felvitték Szent Vitus kegyhelyére. Itt piros cipőt aggattak rájuk, melyet kereszt motívumokkal ékesítettek és szentelt vízzel hintettek be. A bűnös lelkeknek pedig latin inkantációk közepette kellett rituálisan megtisztulniuk.
Ez a gyógyír már hatásosabbnak bizonyult, a táncoló pestis ugyanis 1518 szeptemberében véget ért.

Persze a fentebb említett ásítás és nevetés ragályos lehet, viszont, ha valaki random elkezd táncolni az úton, attól még nem perdülünk mi magunk is táncra. Vagy igen?
Bár az 1518-as strasbourgi eseménysorozat a mai napig megmagyarázhatatlan, a kutatók mégis két lehetséges felvetéssel magyarázták ezt a nem mindennapi járványt. Elsőként egy tömeges anyarozs-mérgezés (ergotizmus) gyanúja lépett fel. Vagyis a strasbourgi lakók étrendjébe egy olyan gombafaj kerülhetett be, mely LSD-szerű hallucinációkat és rángásokat okozott. Jóllehet már az ókori görögök is alkalmazták ezt a hallucinogén szert csoportos rítusokban, azért mégis furcsa elgondolni, hogy négyszáz ember emiatt rángatózna éjjel-nappal.
A másik lehetséges magyarázat John Waller amerikai orvostörténész tollából származik. Ő ugyanis arról számol be, hogy szerinte a 16. századi elzászi várost stressz okozta pszichózis sújtotta, melyet egy táncjárványba torkolló tömeghisztéria koronázott meg.
Az 1518-as táncjárványhoz hasonló tömeghisztériákra volt még példa a történelemben, azonban a strasbourgi eset rejtelmessége kitűnik mind közül. Júliustól szeptemberig majd’ négyszáz ember tombolt együtt szinte a halálig. De hogy valójában mi okozta ezt a jelenséget, azt a mai napig homály fedi.

Portfóliónk minőségi tartalmat jelent minden olvasó számára. Egyedülálló elérést, országos lefedettséget és változatos megjelenési lehetőséget biztosít. Folyamatosan keressük az új irányokat és fejlődési lehetőségeket. Ez jövőnk záloga.